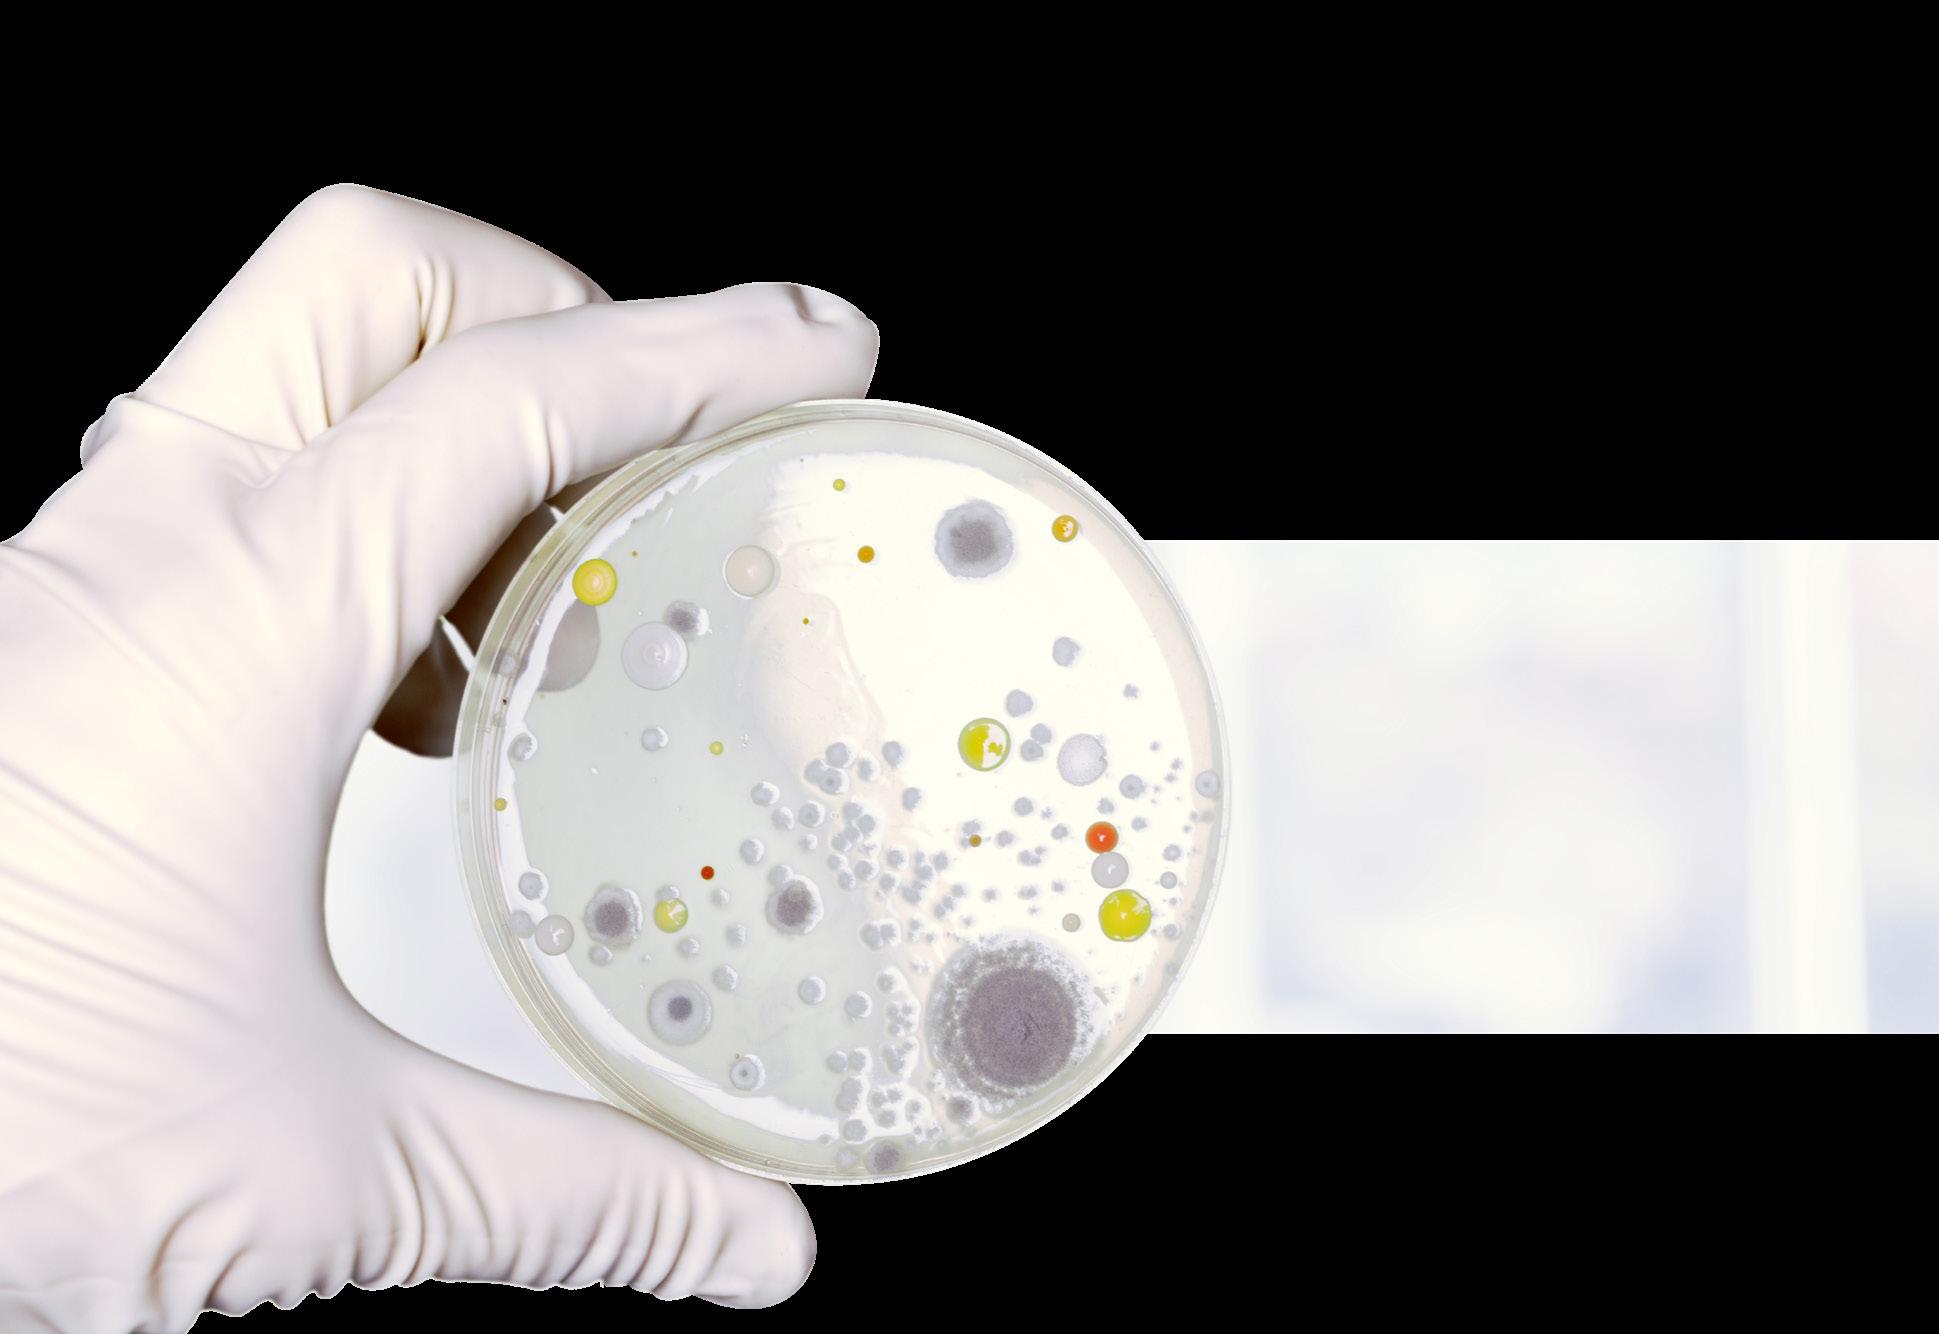

Tailored
• From on-site testing to automated high throughput testing



• LFD, ELISA, SPE, IAC, reusable cartridges
Tailored mycotoxin testing for your needs









• Single or multi-toxin testing options
• Global provider for test kits and compatible equipment From on-site testing to automated high throughput testing















• Single or multi-toxin testing options
• Global provider for test kits and compatible equipment

















dedicated to food safety
• Cer tified reference material, standards and control material



mycotoxin
testing for
mycotoxin testing
testing to automated high throughput testing
tified reference material, standards and control material for







your


















Rotronic
AwEasy – Standalone
https://r-b.io/mycotoxins Mycotoxins_Overview_Brochure_EN_Short version_2021-02.indd 1 25.05.2022 09:14:56 The new AwEasy complements our range of water activity measurement devices perfectly. Measurement probes, penetration probes, laboratory benchtop and handheld devices can be combined flexibly according to your requirements. Bene t from the highest accuracy, e ciency, and easy calibration to optimize processes and ensure product quality. ProcessSensing.com SCAN ME Rotronic AwEasy – Standalone Bluetooth Water Activity Monitor Compact, lightweight and mobile AW Quick for results in 4 – 5 min. Also measures humidity and temperature AwTherm HC2-AW HygroLab AwEasy Auto-report nction The new AwEasy complements our range of water activity measurement devices perfectly. Measurement probes, penetration probes, laboratory benchtop and handheld devices can be combined flexibly according to your requirements. Bene t from the highest accuracy, e ciency, and easy calibration to optimize ProcessSensing.com



mycotoxin testing for your needs
https://r-b.io/mycotoxins ISSN: 2056-8355 foodanddrinknetwork-uk.co.uk Volume 23 • Issue 09 FOOD
R-Biopharm Group – dedicated to food safety Tailored mycotoxin testing for your needs
IAC, reusable cartridges multi-toxin testing options for test kits and compatible equipment material, standards and control material your needs
rom on-site testing to automated high throughput testing
Tailored
• From on-site testing to automated high throughput testing
• LFD, ELISA, SPE, IAC, reusable cartridges
Compact, lightweight and mobile • AW Quick for results in 4 – 5 min. • Easy to use with display • Also measures humidity and temperature • Free smartphone app • AwTherm HC2-AW HygroLab AwEasy Standalone Bluetooth Water Activity Monitor Turn to page 20 VISIT PPMA SHOW 2023 – THE UK’S NO.1 EVENT FOR THE VERY LATEST PROCESSING AND PACKAGING MACHINERY, ROBOTICS AND INDUSTRIAL VISION TECHNOLOGY Showcasing the very latest and best technology in the KNOWLEDGE Draw on the unique knowledge EXPERIENCE Invest with confidence; experience the latest machines PPMA SHOW 2023 The Complete Production Line Event Turn to page 07 RIDA®QUICK R-Biopharm’s products are a valuable tool to check if your food and feed comply with legislation R-Biopharm Group – dedicated to food safety • From on-site testing to automated high throughput testing • LFD, ELISA, SPE, IAC, reusable cartridges • Single or multi-toxin testing options Tailored mycotoxin testing for your needs R-Biopharm Group – dedicated to food safety • From on-site testing to automated high throughput testing • LFD, ELISA, SPE, IAC, reusable cartridges • Single or multi-toxin testing options • Global provider for test kits and compatible equipment • Cer tified reference material, standards and control material Tailored mycotoxin testing for your needs THE ROTRONIC AWEASY -
Tailored
mycotoxin testing for your needs
Bluetooth Water Activity Monitor












Market Leading Cartoning and Sleeving Simple, reliable and robust cartoning and sleeving machinery that is easy to operate, hygienically designed and proven worldwide. We have a machine to suit almost every cartoning and sleeving application. From simple manual cartoners through to automatic high speed wraparound sleevers. Serving the Food, Beverage and Household Goods industries. Get in Touch See us on Stand B10 Give us a call, send us an email and one of our experienced team members will be straight in touch to offer you some further information on our market leading cartoning and sleeving machines. We have a team of both food industry and beverage industry Manufactured in the UK, Used Worldwide 01724 276908 sales@tfreemantle.com tfreemantle.com
EDITORIAL:
Brau Beviale Easyfairs Harford Control Label Expo London Packaging Week Marbles PR PPMA Show Tarsus Group Ltd

ADVERTISEMENT SALES:
KIMBERLEY READ (Advertisement Sales Manager) GINA MADDISON

ACCOUNTS & ADMINISTRATION:
AMANDA JAYNE WALMSLEY EVELYN WOOLSTON
GRAPHICS DEPT:
STUART TURNBULL - Studio Manager RACHEL RILEY - Designer
PUBLISHED BY:
WALTONS PUBLICATIONS LTD 46 HENEAGE ROAD, GRIMSBY N.E. LINCOLNSHIRE DN32 9ES
TELEPHONE:
EMAIL:





01472 359036
Kimberley Read at: kimberley@ foodanddrinknetwork-uk.co.uk or Gina Maddison at: gina@foodanddrinknetwork-uk.co.uk

WEBSITE:
foodanddrinknetwork-uk.co.uk




2056-8347 06
SUBSCRIPTION:
12 issues - £84.00 (inc. postage)
All rights reserved. No part of Food and Drink Network UK Magazine may be reproduced or stored in a retrieval system or transmitted in any form, electronic, mechanical or photocopying, without prior written permission of the publishers. The publishers do not accept responsibility for views expressed, or statements made, or in those reproduced from any other source. No responsibility is borne by the publishers for any errors made in any advertisement, or for claims made by any advertiser which are incorrect. The publishers cannot be held responsible for any breach of copyright arising from any material supplied. This includes copy, design and/or images.
FOOD AND DRINK NETWORK
Tailored mycotoxin testing for your needs
Tailored mycotoxin testing for your needs




• From on-site testing to automated high throughput testing

• LFD, ELISA, SPE, IAC, reusable cartridges
• Single or multi-toxin testing options
• Global provider for test kits and compatible equipment

• Cer tified reference material, standards and control material
Labelexpo Europe 2023 returns to Brussels Expo.

Europe 2023, the world’s largest label and package printing technology trade show is now open.
sleeving solutions
Simple, reliable and robust cartoning and sleeving machinery that is easy to operate, hygienically designed and proven worldwide
16
LONDON PACKAGING WEEK 2023
Easyfairs London Packaging Week: The Highlight of the UK Packaging Industry - September 21 & 22
28
INSTANT BUILDING INSTALLATIONS
Considering an Instant Building? Here are 10 key things you need to consider...
31 TESTING & ANALYSIS
Ensuring Food Safety: Mycotoxin Testing & Eco-Fill Autoclaves 07 PPMA SHOW 2023
Packaging and processing innovations on display at the 2023 PPMA Show. The UK’s largest processing and packaging machinery exhibition, the PPMA Show, returns to the NEC Birmingham in September.
09. Silverson Machines at
PPMA Show This year Silverson will be on Stand E20.
32
18 BRAU BEVIALE 2023
BrauBevaile in top form. After a 4-year break in its exhibition schedule BrauBeviale in Nuremberg will start again from November 28-30, 2023.
HYGIENE
The ultimate wash from New Interfood Partnership Interfood customers can now ensure ultimate hygiene for their processing equipment following the announcement that the Buckinghamshire-based business has signed a new partnership agreement with Colussi Ermes.


25.05.2022 09:14:56 https://r-b.io/mycotoxins 25.05.2022 09:14:56
02 04
us on LinkedIn Copyright © 2023 All Rights Reserved.
Find
the
TWITTER:
ISSN: @fdnetworkuk
UK
Group –
food safety
R-Biopharm
dedicated to
https://r-b.io/mycotoxins Mycotoxins_Overview_Brochure_EN_Short version_2021-02.indd 1 25.05.2022 09:14:56
Group – dedicated to food safety
R-Biopharm
https://r-b.io/mycotoxins Mycotoxins_Overview_Brochure_EN_Short version_2021-02.indd 1 25.05.2022 09:14:56
Asda expands plant-based cheeze range
Supermarket giant Asda is growing its plant-based cheeze selection by adding Applewood Vegan and Ilchester Vegan to its range at stores across the UK.
Applewood Vegan is one of the UK’s most popular plant-based cheeses and is the vegan version of the UK’s number one smoky cheese, Applewood. Earlier this year, Applewood Vegan launched its first plant-based snacking cheeze, Applewood Vegan Minis, which Asda will be stocking alongside the multi-awardwinning Applewood Vegan Grated.
The Applewood Vegan Minis Snacking Net only launched in March and has already won the Gold Award in the Dairy-Free Cheese Alternative category in the International Cheese Awards 2023 last month.

The multi-award-winning Ilchester Vegan Melting Mature Cheddar Block and Slices are also being stocked at Asda stores across the country for the first time. Ilchester Vegan has been described as the “best vegan melting cheeze on the market”.
Applewood Vegan and Ilchester Vegan are produced by Norseland, the UK’s
ATS Packaging takes centre stage at PPMA Show 2023
ATS Packaging will have a major presence at this year’s PPMA Show with two stands that showcase the company’s wide range of packaging machinery for a variety of end markets including personal care, pharmaceuticals, food & beverage, medical, homecare and automotive.
The stands will focus in particular on ATS’s ability to provide turnkey filling line solutions, including bottle unscramblers, liquid filling machines, lidding / capping machines and end of line automated packing systems.

A major highlight will be the company’s ‘turnkey and complete’ end of line Spray Trigger Capping System that offers a complete spray trigger feeding, capping, robotic cartoning / packing / sealing and palletising solution. The advanced system provides radial control and alignment of spray trigger devices relative to container orientation to ensure fast and accurate placement via an automatic trigger feeding system.
The Spray Trigger Capping System is the latest addition to ATS’s range of advanced capping machines, which will also be on display at the show. All incorporate high-precision tightening technology featuring fully programmable torque, speed, applied force and vertical positioning of the capping head to provide a guaranteed tightening operation with factory networked closure result storage (CSR).
In addition, ATS will demonstrate its FBL range of jar lidding and filling machines for the food and drink sector, which ensure the fast and efficient automatic filling and tightening of glass jars and metal Twist-Off (TO) and Press-on, Twist-Off (PT) closures, with or without a vacuum seal. They are suitable for a wide variety of products including mayonnaise, tomato ketchup, cooking sauces, pickled vegetables, jams and honey.

All ATS-designed solutions also offer fast changeovers between different formats thanks to the adoption of SMED (Single Minute Exchange of Die) principles that allow change-parts to be changed over quickly in under 10-minutes with minimal fuss and instant return to maximum production efficiency.
Other ATS packing line solutions on display include a range of GMS versatile bottle unscramblers that allow multiple container formats to be carefully sorted and orientated in a single machine system, and the SK Pharma range of highperformance and durable Mixing Vessels.
The PPMA Show will also provide the first opportunity for ATS to demonstrate the latest automated pallet wrapping machines from the newly established Matco International UK The dual stand format at stands H42 and J40 incorporates a specially created social area for visitors, offering snacks and a bar.
For further information on Advanced Tooling Systems UK Ltd

Tel +44 (0) 1622
678143
Email: info@ ats-packaging. com
leading blended and snacking cheese producer. Talking about the new listings, Ffion Davies, Senior Brand Manager for Applewood Vegan and Ilchester Vegan, said: “Asda has been a pioneer for our plant-based brands. Asda was the first supermarket group to sell Applewood Vegan which it launched back in October 2019. It proved to be so popular with vegans - and flexitarians - when it launched, that 40% of the Asda stores that stocked it sold out on the first day. So, we are over the moon that Asda is going to be extending its range to stock our first plant-based snacking range, Applewood Vegan Minis, and our very popular Ilchester Vegan.”
Applewood Vegan Minis and Applewood Vegan Grated are now available to buy in Asda, while Ilchester Vegan Melting Mature Cheddar Block and Slices will be launching in Asda later this month.
Babcock Wanson Completes Turnkey Steam Project for UK’s Largest Centralised Kitchen
Industrial process heating equipment and solutions specialist Babcock Wanson has completed a turnkey project to supply steam, via its BWD30 fire tube boiler, to cookers at IRC Cucina’s new Trafford Park centralised kitchen.

Working within the Iceland Foods umbrella, IRC Cucina supplies product into a diverse restaurant group. Its newly-established site at Trafford Park, which has benefited from a major investment, is now the UK’s largest centralised kitchen and will enable the company to not only produce high quality, consistent food, but will also allow for future growth.
Babcock Wanson was brought in to the project at an early stage, as IRC Cucina’s General Manager, Robert Lishman explains: “This was a relocation of a complex dual site operation into a larger single site operation, post build. We moved at a pace with this project and started it without an end to end system. Consequently, as we were building the kitchen, our plans changed. With each change Babcock Wanson risk assessed, consulted with the various parties, and adapted to our plans. They were very accommodating. They are our go to supplier. In fact, they are more than a supplier as their specialist knowledge and expertise extends beyond just the equipment and into the legal implications of the processes involved, so we rely heavily on them for compliance.”
The focus of Babcock Wanson’s work at IRC Cucina’s Trafford Park site has been on the sous vide and sauce cooking equipment, which requires large volumes of steam supplied instantaneously. Babcock Wanson’s BWD30 fire tube steam boiler, with its three pass design, readily meets this need, providing high quality dry steam with availability higher than 97%.
As you would expect from a Babcock Wanson boiler, it is compliant with all relevant environmental standards and is reliable and robust. For more information, please contact Babcock Wanson on 020 8953 7111 or info@babcock-wanson.com or go to www.babcock-wanson.com
News Network 02 | foodanddrinknetwork-uk.co.uk
General
Thrifty high-performer

The world’s first ErgoBloc L wet-end system with an hourly output of 100,000 0.5-litre PET or rPET bottles is a big hit with our customers.
Within just a few months, international clients ordered nearly 30 of these high-performers.
Since it was launched over 14 years ago, the Krones ErgoBloc L has taken care of the blow-moulding, labelling, filling and closing of PET bottles in a single, highly efficient system. Its efficiency was once again demonstrated last September at the drinktec, the world’s biggest trade fair for the beverage and liquid-food industry, where a block-synchronised system was able to produce 100,000 bottles per hour for the first time.
Just under 30 of these high-speed blocks were sold within a few short months, six of them to customers in the Middle East. This goes to show that the ErgoBloc system meets the needs of beverage producers all over the world, both by achieving the required performance and by helping to put the production process on a more sustainable footing.

Higher outputs result in improved sustainability




When compared to a 72,000-bph block, the new ErgoBloc L, rated at 100,000 bottles per hour, not only boasts better performance, it also provides substantial energy savings. Technical upgrades in the heating tunnel, for example, reduce energy consumption by more than ten per cent and the amount of compressed air in the stretch blow-moulding process by 20 per cent. What is more, up to 3,600 tons of CO2 per year can be saved if 100 per cent rPET is used.


The high-speed ErgoBloc L reduces both media consumption levels and the footprint required for its installation. It needs up to 70 per cent less space than conventional systems. The block also scores highly when it comes to process dependability. State-of-the-art automation technology ensures that it continues in operation even if one of the two fillers fails, and that the blow-moulder is emptied, thus preventing an immediate standstill in the block and minimising the scrap rate.

Food and Drink Network UK, 133
186 mm, Sustainability F, CC-en91-AZ299 08/23 CC-en91-AZ299_08-23.indd 1 02.08.2023 11:29:56
x
Krones foodanddrinknetwork-uk.co.uk | 03
Domaine du Météore collaborates with Van Gogh Museum

Domaine du Météore have launched a range of wines in collaboration with the Van Gogh Museum.
This exciting development sees Domaine du Météore and the Van Gogh Museum create two organic wines inspired by the world-famous artist, Vincent van Gogh, which capture the essence and beauty of the South of France. Working with the Van Gogh Museum, Domaine du Météore is launching the wines which represent the link between nature and art, the South of France and Vincent Van Gogh himself. Just as Vincent captured the essence and beauty of these southern landscapes in his paintings, Domaine du Météore has created wines born from the same terroir. The organic white wine takes its name Sunflowers from the famous sunflower picture painted near Domaine du Météore which is located in Languedoc. The red wine is called Avenue of Poplars in Autumn after the beautiful autumn landscape with tall poplar trees lining the roads, typical of the Languedoc region. As an organic wine Domaine in the South France, with its vines growing in and around a 10,000 year old meteorite crater, Domaine du Météore has a unique natural setting. Both the paintings and the Domaine highlight the importance of
Yorkshire whisky business releases a distillery exclusive limited edition whisky
The team at Yorkshire’s first single malt whisky distillery, Spirit of Yorkshire, launched a limited edition special release whisky to celebrate Yorkshire Day. Filey Bay Yorkshire Day 2023 Special Release is the fourth bottling in a limited run of releases that are launched annually to celebrate the iconic day.
Of the launch, Spirit of Yorkshire’s Whisky Director, Joe Clark said: “Outside of the single cask releases, Filey Bay Yorkshire Day is the rarest whisky we release each year.
“Matured in ex-Madeira and ex-Bourbon casks, this is the first example of Filey Bay whisky matured in Madeira casks in the UK and is made from some of our oldest, rarest whisky.

“It’s very different to previous Yorkshire Day releases which were all built around sherry maturation. It’s incredibly fruity and honeyed. Crunchie bars, Jamaican ginger cake and stone fruits are all present, with apricot and peach particularly noticeable on the finish.”
Co-Founder, David Thompson is pleased with the flavour profile of the distillery’s latest single malt whisky release: “Filey Bay Yorkshire Day 2023 is fruity and complex with flavours of honeycomb, gingerbread, citrus and stone fruits. With only 1500 bottles available, Filey Bay Yorkshire Day 2023 is amongst our rarest whisky releases to date. It’s also one of our oldest whiskies to be bottled so far and it’s highly likely that it will sell out quickly.” Filey Bay Yorkshire Day 2023, 55% abv is sold with a Special Release tube and costs £90. It’s available exclusively from the distillery shop and online at spiritofyorkshire.com. A limited number of bottles will be released to selected on-trade venues for dram sales. Spirit of Yorkshire is a true field-tobottle distillery and one of only a few distilleries that use 100% homegrown barley to produce its single malt whisky that is available throughout the UK and in a growing number of export markets.
For further information on MugShot visit www.mugshot.co.uk
nature and its influence on artistic and viticultural creations. The Sunflowers white wine is a blend of organic Rousanne and Viognier grapes typical of the region where the Domaine is located. The Avenue of Poplars in Autumn red wine is a blend of organic Syrah, Grenache and Mourvèdre grapes.
Domaine du Météore’s winemaker, Simon Frech, says, “Van Gogh’s paintings and our wines are both the product of the same terroir of Mediterranean garrigue. Van Gogh was captivated by the special light that we have in our region; light that makes our grapes grow until perfect maturity. What we do when we make the wine is the same as Van Gogh, demonstrating the beauty of the South of France.”
For information visit www.domainedumeteore.com/our-wines/
The recipe refresh aims to capitalise on the remaining summer months with the popular cocktail, offering a bolder colour and smoother finish. The Cocktail Co, a producer of ready-to-drink (RTD) cocktails, has announced a recipe refresh for its Cosmopolitan RTD cocktail, which has now launched. The Cocktail Co is renowned for its bar-quality, pre-made cocktails. Its new and improved Cosmopolitan recipe sees a reduced amount of cranberry, with a touch more citrus to allow the orange notes to come through on the palette, so the cocktail tastes even smoother than before.
The colour and consistency have also been improved to produce a brighter, bolder colour and allowing the orange flavour-profile to take the spotlight. The recipe development follows recent research which shows that the Cosmopolitan remains within the UK’s top ten cocktail serves[1], with Google searches for ‘cosmopolitan cocktail recipe’ up 361% in the last week alone.
Abby Matthews, director of The Cocktail Co, explains, “Our main value here at The Cocktail Co is to create truly bar-quality drinks that can be enjoyed from the comfort of our customers’ homes. And so, we’re constantly challenging ourselves to keep developing our products, which so many people love, so that they’re the best they can possibly be.
“Our Cosmopolitan is one of our best-selling products (which will come as no surprise given the data), so we’re excited to unveil our new, brighter, smoother recipe to customers as we know it will be even more of a hit than it already was!
“The new recipe has hit shelves in time to capitalise on the remaining summer months and upcoming Bank Holiday – the perfect drinking opportunities.”
The Cocktail Co’s Cosmopolitan has an RRP of £5 and can be purchased via The Cocktail Co’s website, or in selected Booths and Morrisons stores.

For more information about The Cocktail Co, please visit: https://the-cocktail-co.com/product-category/cocktails/.
[1] https://www.thespiritsbusiness.com/2023/04/google-data-reveals-uks-top-10-cocktails/
Liquid Gold” Kyrö Malt Whisky Wins 3-stars in Great Taste 2023!

Say hello to the first Rye Malt Whisky to ever take home a Great Taste 3-star award.
Kyrö Distillery Company, the award-winning whisky, gin and cream liqueur brand from Finland, has won 3-stars in this year’s Great Taste accreditation scheme for its Kyrö Malt Whisky - the first Rye Malt Whisky to take home an award over the years! The all-rye Finnish distillery was founded in a sauna in 2012 by five friends who dreamed of creating rye-based spirits from the quiet town of Isokyrö. It celebrated its ten-year anniversary last year and has headquarters in Isokyrö, Helsinki, Berlin, and London.
This year, 14,195 products were put through Great Taste’s rigorous blind judging process. Kyrö Malt received some outstanding feedback from the expert panel of judges: “It dances on the tongue and is a whisky that keeps on giving with lots of flavours.”; “The finish is complex with a warming spice and urges you to go back for more. An excellent product”; and “This whisky is liquid gold! Being recognised
with any Great Taste award, besides a 3-star, means so much to us. It makes all the hard work and determination in the brand and our products worth it! Our Kyrö Malt has won the hearts of many whisky drinkers around the globe already but we’re chuffed to hear its come out top. Great Taste is the most recognised accolade for taste and quality in the food and drink industry, so it’s a huge moment for us!” comments Miika Lipiäinen, co-founder of Kyrö Distillery Company. Recognised as a stamp of excellence and actively sought out by food lovers and retailers alike, Great Taste, organised by the Guild of Fine Food, values taste above all else. All products in the line-up for judging are blind tasted: every product is removed from its packaging so it cannot be identified, before entering a robust, layered judging process.
Product News
04 | foodanddrinknetwork-uk.co.uk
The Cocktail Co reveals new-andimproved RTD Cosmopolitan
New Innovations
A menu of options for an easier Christmas
A menu of options for an easier Christmas
Royal Mail offers reliability, convenience and value ahead of the essential festive season
Royal Mail offers reliability, convenience and value
ahead
of the essential festive season
Food and drink manufacturers and retailers know that summer isn’t just a time for barbecues –it’s also time for festive planning.
Food and drink manufacturers and retailers know that summer isn’t just a time for barbecues –it’s also time for festive planning.
“When our customers are preparing for Christmas, so are we,” says Jon Nicholson, UK Sales Director of Royal Mail. Reliable deliveries need a strong network, and Royal Mail have already put capacity in place to support extra food and drink orders from coffee subscription boxes to craft gin.
“We’ve opened up a new Super Hub which can sort an extra 850,000 parcels a day,” explains Nicholson. “So we’re more able to flex to seasonal demand and cater to our customers’ needs.”
“When our customers are preparing for Christmas, so are we,” says Jon Nicholson, UK Sales Director of Royal Mail. Reliable deliveries need a strong network, and Royal Mail have already put capacity in place to support extra food and drink orders from coffee subscription boxes to craft gin. “We’ve opened up a new Super Hub which can sort an extra 850,000 parcels a day,” explains Nicholson. “So we’re more able to flex to seasonal demand and cater to our customers’ needs.”
In addition to their 85,000 trusted posties, Royal Mail are also adding more seasonal sorting staff and vans to help tackle the rush.
In addition to their 85,000 trusted posties, Royal Mail are also adding more seasonal sorting staff and vans to help tackle the rush.
What else is new in time for Christmas?
What else is new in time for Christmas?
“We know that customers and retailers are having to place a bigger focus on value this year, so we wanted to make that easier,” says Nicholson.
“We’ve introduced more competitive rates for Tracked parcels up to 30kg. We also now deliver on a Sunday for the same price as any other day of the week. Which means if retailers offer Royal Mail Tracked 24® or Royal Mail Special Delivery Guaranteed®, shoppers can order their favourite foods and beverages on Saturday in time for a celebration the next evening. Perfect for fulfilling last minute orders and staying competitive.”
“We know that customers and retailers are having to place a bigger focus on value this year, so we wanted to make that easier,” says Nicholson. “We’ve introduced more competitive rates for Tracked parcels up to 30kg. We also now deliver on a Sunday for the same price as any other day of the week. Which means if retailers offer Royal Mail Tracked 24® or Royal Mail Special Delivery Guaranteed®, shoppers can order their favourite foods and beverages on Saturday in time for a celebration the next evening. Perfect for fulfilling last minute orders and staying competitive.”
When it comes to food and drink, Royal Mail know how critical first-time delivery can be, which is why Tracked services come with notifications and full tracking. “But if customers aren’t at home, we’ll now auto-redeliver as standard – so retailers don’t have to deal with as many enquiries at such a busy time,” says Nicholson. And for those bubbly beverages that require age verification at the doorstep, Royal Mail offers that too as an optional extra with Tracked and Special Delivery Guaranteed.
When it comes to food and drink, Royal Mail know how critical first-time delivery can be, which is why Tracked services come with notifications and full tracking. “But if customers aren’t at home, we’ll now auto-redeliver as standard – so retailers don’t have to deal with as many enquiries at such a busy time,” says Nicholson. And for those bubbly beverages that require age verification at the doorstep, Royal Mail offers that too as an optional extra with Tracked and Special Delivery Guaranteed.
“We also know people really care about the sustainability of what they eat, where it’s come from and how it’s reached their dining table. We’re proudly the greenest delivery partner in the UK, with the lowest recorded emissions per parcel,*” Nicholson explains. “Environmental considerations are at the forefront of our business, from our feet-on-the-street delivery model, to our alternative fuel vehicles and waste reduction initiatives.”
“We also know people really care about the sustainability of what they eat, where it’s come from and how it’s reached their dining table. We’re proudly the greenest delivery partner in the UK, with the lowest recorded emissions per parcel,*” Nicholson explains. “Environmental considerations are at the forefront of our business, from our feet-on-the-street delivery model, to our alternative fuel vehicles and waste reduction initiatives.”
Royal Mail aren’t only the greenest, but also the most trusted carrier among major UK delivery companies.** Jon Nicholson thinks this helps set them apart: “We’ve got the backing of consumers, and now we have the extra capacity to really deliver a convenient, reliable and great value service. When deliveries matter – and at Christmas they really do – it has to be Royal Mail.”
Royal Mail aren’t only the greenest, but also the most trusted carrier among major UK delivery companies.** Jon Nicholson thinks this helps set them apart: “We’ve got the backing of consumers, and now we have the extra capacity to really deliver a convenient, reliable and great value service. When deliveries matter – and at Christmas they really do – it has to be Royal Mail.”
To find out more about Royal Mail’s reliable delivery and return options, visit royalmail.com/foodanddrinknews
To find out more about Royal Mail’s reliable delivery and return options, visit royalmail.com/foodanddrinknews


* Based on publicly available average reported gCO2e per parcel from other UK parcel operators.
** Mintel Online Retailing Consumer Report 2023.
© Royal Mail Group Limited 2023. All rights reserved.
* Based on publicly available average reported gCO2e per parcel from other UK parcel operators. ** Mintel Online Retailing Consumer Report 2023. © Royal Mail Group Limited 2023. All rights reserved.
Labelexpo Europe 2023 returns to Brussels Expo
Registration for Labelexpo Europe 2023, the world’s largest label and package printing technology trade show, is now open.

This will be the first time Labelexpo Europe has been held at Brussels Expo since 2019. From 11-14 September, the biennial show will feature hundreds of live demonstrations, product launches, two expert-led masterclasses and special events focused on automation and flexible packaging.

Aimed at label and flexible packaging converters, brand owners and packaging designers, Labelexpo Europe 2023 covers nine halls with over 600 exhibitors across four days. Leading suppliers taking part include ABG, Avery Dennison, BOBST, Domino, Durst, Epson, Fujifilm, Gallus, HP, Kocher & Beck, Konica Minolta, Mark Andy, MPS, Nilpeter, OMET, and Xeikon.
Alongside the exhibition, visitors will get the opportunity to attend two expert-led masterclasses organised by The Label Academy, an Automation Arena, and a Flex Pack Trail. The popular educational program will comprise of two half-day masterclasses which will cover flexible packaging and sustainable labels and packaging. Additionally, visitors will also get the chance to attend the Dieline Forum, a two-day design conference that will explore the latest trends and innovations shaping the brands of tomorrow.
At the Flex Pack Trail, visitors will be able to learn more about digital and conventional press technologies, flexpack material constructions, coating, laminating, ink and curing requirements, in-line and near-line decoration options, QC and migration testing.
The Automation Arena features a full ‘lights out’ production workflow, from file creation to digital printing, converting and inspection. The participants include CERM, Esko, Xeikon, KURZ ,Grafotronic and Fedrigoni Self-Adhesive. As well as automated setup and inspection of both printing

and converting processes, the CERM MIS will collect real-time information via a Cloud portal which visitors will be able to monitor on their own smart devices. CERM will demonstrate printing of closing labels on each roll on the turret rewind.
A new feature for Labelexpo Europe is Flexo’s Future – ECG, a series of presentations and guided tours on Expanded Colour Gamut (ECG) printing. Daily presentations by renowned ECG expert Dr Kai Lankinen will take place on the show floor, examining all aspects of fixed colour palette printing, where up to seven inks (CMYK+OGV) are used to reproduce spot colours. Taking place on the first evening of the show, 11 September, is the Label Industry Global Awards ceremony, themed as ‘Crowning the Industry’s Champions’. The awards highlight the key achievements and successes of individuals and companies working in the label and package printing sector.
Labelexpo Europe 2023 is again strongly supported and endorsed by trade bodies FINAT, EUWID, Febelgra, SPPES, UNFEA and VskE.
Exhibitions Labelexpo Europe 2023 06 | foodanddrinknetwork-uk.co.uk An early bird booking discount applies until 25th August. To register, visit www.labelexpo-europe.com/
Photo courtesy of Studio Vercammen
VISIT PPMA SHOW 2023 – THE UK’S NO.1 EVENT FOR THE VERY LATEST PROCESSING AND PACKAGING MACHINERY, ROBOTICS AND INDUSTRIAL VISION




SCAN THE QR CODE TO J0IN US
TECHNOLOGY
Showcasing the very latest and best technology in the processing and packaging industry – all under one roof.

KNOWLEDGE
Draw on the unique knowledge of hundreds of exhibitors to tailor the solutions right for your business.
EXPERIENCE
Invest with confidence; experience the latest machines on the market before you buy – only at the PPMA Show.
Packaging & processing innovations on display at the 2023 PPMA Show
The UK’s largest processing and packaging machinery exhibition, the PPMA Show, returns to the NEC Birmingham in September. This is the ultimate event for anyone involved in the industry to see the latest processing and packaging machinery, robotics and industrial vision systems. The exciting three-day event on 26-28 September will be showcasing the latest innovations to visitors from numerous different sectors involved in processing and packaging. Some of these sectors include food and beverages, pharmaceuticals, household products and toiletries, building materials and supplies, pet care, and micro-brewery and distilleries as well as contract packers and more.


In less than two months, the show opens its doors to thousands of visitors, who will have the opportunity to hear from a range of dynamic speakers. The content rich seminar programme topics will include food packaging innovation, the importance of sustainability, and how manufacturing is evolving to meet the needs of the processing and packaging sector.
The show already has a line-up of exciting keynote speakers, including Cassandra Stavrou MBE, Proper Snacks Founder, who shares her entrepreneurial journey and the importance of innovation in processing and packaging machinery. Joining her will be Dimitrios Spiliopoulos, Industrial IoT Lead for Manufacturing at Amazon Web Services, and Philip Hooker, VP Strategic Programmes at Cumulocity IoT, who will share their vision and expertise in empowering packaging and processing enterprises to tackle critical smart production and smart connected product challenges head-on.
This must-attend show will offer plenty of brilliant meeting opportunities with over 300 exhibitors, representing more than 2,600
brands. In addition, visitors can expect to see numerous exciting new product launches and live demonstrations at the show. This provides an ideal chance to get an up-close look at the latest technological innovations and products helping to shape the various markets.
Scott McKenna, Group Exhibitions and Membership Manager at the PPMA Group, said: “We are pleased to have once again such an array of exhibitors representing the full spectrum of the industry. These leading companies will be eager to demonstrate to visitors how they can improve their businesses with the latest cutting-edge technologies. This can help businesses stay ahead with the latest trends, improve efficiency, and make better use of resources.”
Here are just some of the exhibitors taking part in the show: Reiser, ULMA, Omori UK, and Ishida Europe. Visitors can take advantage of the comprehensive exhibitor listing on the PPMA Show website to help plan their visit www.ppmashow.co.uk/exhibitors-2023#/ exhibitors/
The PPMA Show will offer a rare opportunity for visitors to see a complete production line in action from start to finish, from labelling, filling and packaging to processing, robotics, automation and industrial vision systems.



Visitors can also connect with leading industry experts and gain access to an invaluable source of knowledge and insight. These experts can provide the latest information and trends, help identify opportunities and challenges, and offer guidance and advice. In addition, whether looking to make new business connections or network with industry peers, this is the perfect event for all.

Exhibitions
PPMA 2023 08 | foodanddrinknetwork-uk.co.uk
Register for your free ticket: https://ppma-show-2023-visitor.reg.buzz/website
Silverson Machines at the PPMA Show
This year Silverson Machines will be on stand E20 at the PPMA show. On the stand will be a range of high shear mixing equipment, from smaller-scale Laboratory mixers to full scale production mixers such as the Flashmix powder/liquid mixer.

Laboratory Mixers
For mixing small batches from 1ml up to 12 litres, Silverson has a range of Laboratory mixers suitable for a wide range of mixing processes. All Silverson rotor/stator mixers come with a range of easily interchangeable workheads, which allow one mixer to perform many mixing tasks which would otherwise need several pieces of mixing equipment. Silverson Laboratory mixers can blend, emulsify, homogenise, disintegrate, dissolve and deagglomerate, and mix in-line with flow rates up to 20 litres/minute using an In-Line mixing assembly.
In-tank mixers
For in-tank mixing of volumes up to 30,000 litres Silverson supplies in-tank Batch mixer models. Capable of performing all of the same mixing process as Silverson Laboratory mixers, it is possible to reduce mixing times by up to 90% when using high shear Batch mixers as opposed to traditional mixing methods such as stirrers or agitators.
The Silverson Ultramix in-tank mixer is designed for applications that are beyond the capabilities of a conventional agitator or stirrer but do not necessarily require the intense high shear of a Silverson rotor/stator mixer. Ideal for rapidly wetting out powders, the vigorous mixing action is capable of moving the entire contents of vessels even in difficult shaped containers.
Laboratory-scale In-Line mixing
Silverson will be displaying production-scale In-Line mixers as well
up to 12 in-line litres/minute, excellent scaling
up to
as demonstrating working benchtop models such as the VersoUHS-HV.
The Verso-UHS-HV is a laboratory-scale In-Line mixer designed for mixing high viscosity products. It incorporates the same unique and innovative ‘pumping rotor’ design as the production scale HV In-Line mixers. This substantially increases its self-pumping capacity, allowing it to process products such as gels, creams, sauces and gum solutions on a laboratory scale.

A conversion kit is available allowing the Verso-UHS-HV to be configured as an FMX5 Powder/Liquid mixer. This kit increases the versatility of the machine, allowing one mixer to be used as a Laboratory scale High Viscosity In-Line mixer or Powder/Liquid mixer.

Powder/Liquid mixing
For mixing large quantities of powder, Silverson developed the Flashmix. Unlike many powder/liquid mixers, which use vacuum to pull in powder, the Flashmix literally forces powder into the liquid stream. This not only allows it to disperse and hydrate large volumes of powders, it means it can be used at higher temperatures and with higher viscosity mixes.
Flashmix Powder/ Liquid Mixer
PPMA 2023 foodanddrinknetwork-uk.co.uk | 09 Visit Silverson Machines on Stand E20 | www.silverson.com | sales@silverson.co.uk
Laboratory for the applications Silverson Mixers
These are just a few of the mixer options available in the Silverson product range, you can find more information on additional models on the Silverson website.
L5M-A Laboratory Mixer
In-tank Batch Mixer


































Visit us at PPMA 2022 Booth C70 markem-imaje.com Printer Intelligence. Packaging Intelligence. Brand Intelligence. Intelligence, beyond the mark. Smarter printers, packaging operations and brand protection solutions to connect and protect every product— from production to your consumer’s hands. PPMA-2022_186x270.indd 1 7/19/22 3:34 PM Visit us at PPMA 2023 Booth C70 Exhibitions PPMA 2023 10 | foodanddrinknetwork-uk.co.uk
Ensure brand protection for the candy market with laser marking

With growing consumer awareness and evolving regulatory requirements driving the need for greater traceability, transparency and thus brand protection, there is a shift towards additional data embedded within product coding on candy box packaging. Coders must keep pace by maintaining print quality on the newer, more sustainable materials while enabling manufacturers to store increasing amounts of variable information on products.
Candy market coding is advancing far beyond lot and expiry codes to include additional “smart” data embedded in serialized 2D DataMatrix and QR codes including the new GS1 Digital Link standard, the US FDA’s FSMA Rule and the EU’s Wine Regulation to name a few. These shifts provide greater product information, traceability and even promotional codes and late-stage customization. In order to meet market and regulatory demands, the Markem-Imaje SmartLase ® laser printer solutions, and new UV printers, respond to these challenges by offering superb code quality and compliance with local and international regulations and standards plus efficiency on all substrates, including mono-materials and foils composed of largely recycled materials.

A significant aspect of consumers’ emotional connection with trusted confectionery brands is enjoying the same experience every time. Consistency of quality, taste and presentation is key to continued loyalty. Public responses to changes in product formula, shape or packaging is proof of that. Manufacturers need to respond to this by assuring reliability at every stage of the production process. An important aspect of this is packaging every product to the same high standard each time. This requirement for exceptional reliability even at high volumes is being met by the Markem-Imaje SmartLase laser printers as they provide patented Intelli’Arc® scribing and onboard Intelli’Cool® for faster coding with greater uptime, reliability and throughput at higher duty cycles.
Counteracting



In 2022, the U.K. Food Standards Agency reported a sharp rise in counterfeit chocolate. This concerning trend has the potential to cause serious harm to customers and to brand perception. Counterfeiting poses significant risks to consumer safety and confectionery brands, not only due to fake products being made in facilities that do not meet rigorous food safety standards, but also because of the potential presence of allergens without the appropriate labelling. High quality, trackable code has a significant role to play in the fight against counterfeiting. Laser marking

solutions apply durable, high contrast codes that do not rub off or fade over time, ensuring lifetime traceability of products and reducing the impact of counterfeiting.
Safeguarding well-loved
Confectionery occupies a special place in the consumer market. From a celebration cake to a favourite chocolate bar, it’s a sector in which trusted products are perceived as an accessible luxury or a treat, even during difficult times. This is a space in which trust is paramount, so the stakes are high for confectionery companieseven more so with the rise of counterfeiting and shifting attitudes to healthy eating and environmental issues. A hard won and well-established reputation can be damaged significantly by a single incident, whether that is a poorly managed product recall, a sudden release of fakes, or a change to product taste due to new manufacturing conditions. Because while every great confectionery brand is built on trust, it only takes one highly publicized product recall or food safety failure to undermine it. By working with an expert partner to adopt coding solutions proven to address brand protection challenges such as product traceability, safety and consistency, candy market companies can ensure that trusted products remain exactly that.
To read more about how the Markem-Imaje laser marking solutions for candy packaging and how they can help brand protection, please download our Confectionery brochure via markem-imaje.com
Printer Intelligence.

foodanddrinknetwork-uk.co.uk | 11
Visit Booth markem-imaje.com
Intelligence, beyond Smarter printers, and brand protection connect and from production PPMA-2022_186x270.indd 1 Visit us at PPMA 2023 Booth C70 Markem-Imaje PPMA 2023
product consistency
Ensuring
counterfeiting
brands For further information visit markem-imaje.com
5 Reasons to Partner with an Established MIS/MES Provider
Build or Buy?
The manufacturing sector has been under significant cost pressures over the past three years due to Brexit, the pandemic, and the war in Ukraine.
Companies are actively seeking ways to enhance productivity and reduce production costs. Many IT departments have begun developing in-house software solutions to reduce costs, rather than making additional investments to purchase external MIS/MES systems.
If cost savings are your goal, creating your own software solution is often not the best route to take. Here’s why (in fact 5 Whys, together with 5 Why Nots):
1. UNCERTAIN RISKS AND COSTS
Developing an in-house system presents great risks of exceeding the project’s scope, budget, and timelines, which could even threaten to put the business into administration. McKinsey revealed that more than 50% of IT projects exceed their budget by 45%, surpass their scheduled timeline by 7%, and fall short of delivering 56% of the predicted value. Worryingly, around 17% of IT projects deteriorate to such an extent that they imperil the very survival of the company.
….but when you choose a partner
Choosing an off-the-shelf MIS/MES solution that can be customised to your specific business needs emerges as a wiser strategy. This approach not only helps conserve valuable time, financial resources, and risk, but it can also play a crucial role in preventing potential pitfalls.
2. RESTRICTED INTEGRATION AND SCALABILITY
Your IT department might not cover all operational improvement areas within complex factory operations.
Developing homegrown systems could lead to multiple research areas, consuming time and capital. For instance, while your IT department might focus on creating a production performance tracking dashboard, addressing energy usage becomes another crucial requirement.
….but when you choose a partner

Highly developed and well proven MIS/MES like Harford’s scales across the entire factory, providing real-time data for instant performance adjustments. All production-related information,

Specialist View
12 | foodanddrinknetwork-uk.co.uk
During the first half of 2023, 56 food and drink companies went into administration, constituting 9% of the total UK administrations for this year according to Food Manufacture.
An article By Roy Green, Harford Control Ltd. September 2023
such as quality, performance, energy usage, labour, and wastage, is available within a single real-time system. This empowers your operators to make immediate adjustments to enhance performance.
3. CONSTRAINED SIGNIFICANCE OF REAL-TIME DATA ANALYTICS
While your IT department might develop a dashboard to track OEE (a very simple calculation at worst), can actionable insights be derived from the data? Does a drop in OEE from 65% to 40% hold significance for your operators? What steps can your operators take in response? It’s likely that in-house software might not be able to provide the necessary root cause analysis required for data-driven actions.

….but when you choose a partner
Harford’s end-to-end MIS/MES, real-time information is displayed across integrated networks and large TV screens in the production area, allowing you to monitor and trace every aspect of your production processes, from raw materials to finished products. We provide the granularity that you need to drill down to the root cause of your downtime. Both managers and operators can act immediately, based upon real-time actionable information, without the guesswork.
4. LACKING MAINTENANCE AND SUPPORT
When building a system in-house, staff training becomes essential. Employee turnover is a common occurrence in any business, making it difficult to maintain a clear record of the system’s development and how to address potential future errors. If an error arises, your IT department might face uncertainty about whom to consult.
….but when you choose a partner
Opting for a dedicated solution provider offers the expertise and support you require. We provide 24/7 local support across 6 continents: Europe, North America, South America, Africa, Asia, and Australia. Our engineers are often situated near your factory, ensuring rapid response to your needs. In cases where errors can’t be resolved remotely, we are prepared to visit your site and assist.
5. CONTINUOUS IMPROVEMENT DEMANDS SUBSTANTIAL
INVESTMENT
While building software in-house, your IT department might create essential add-ons and integrations, adapting to emerging challenges and technological advancements. This demands ongoing investment in research and development, with no assurance of each add-on adding value. Some companies find it challenging to stay current with technology, leading to reduced market share or potential bankruptcy.
….but when you choose a partner

Working with a solution supplier helps save these costs, allowing you to concentrate on your core business. At Harford, we allocate 35% of turnover each year to research and develop our MIS/ MES systems, based on customer needs and market demands. We have expanded our solutions including LIMS, energy tracking, labour wastage and monitoring, adding to our existing successful solutions.
The continuous development of our performance improvement systems for over 55 years keeps us at the leading edge of realtime factory floor MES technology. No other single company has created such an impressively integrated set of production modules which so seamlessly work together to form the most comprehensive picture of factory performance.
Success Stories: Real Results and Tangible Savings

Don’t just take our word for it. Look at what our customers have said: “One year after implementation and Harford has supported us in reducing our bottling losses to less than 0.1% and has taken our overall end to end liquid losses down by more than 50%.
This alone has delivered sufficient savings back to the business to pay for Harford. Plus, we now have the added benefit of seeing real-time performance data, that is beginning to yield greater efficiencies on our production lines, as a result of our ability to identify and tackle the biggest causes of downtime.”
Tony Brewerton, Plant Director, Loch Lomond Distillers
By installing the Harford system and utilising it efficiently, we can help you save on production costs without any additional capex requirements beyond the initial cost of the Harford system itself. Given the proven effectiveness of Harford MIS/MES, why invest in developing an in-house solution that might not yield results?
“Success is not mandatory, neither is survival.” Edwards Deming
Choose a Cost-Effective Approach
Opting for a reliable solution supplier is much more cost-effective for your factories, offering benefits like risk and cost monitoring, advanced functionality scalable across your entire factory, realtime drill-down data insights, maintenance, support and future readiness. To learn more about the power of Harford’s End-to-End MIS/MES, get in touch with our Business Improvement Managers to help us understand your performance objectives.
We will also be on Stand B46 during the PPMA Show at the NEC in September. Visit our stand to see how we assist our clients in focusing on continuous improvement and retaining their competitive advantage.
PPMA 2023 foodanddrinknetwork-uk.co.uk | 13 +44 (0) 1225 764461 www.harfordcontrol.com
Spiroflow launches next-generation twin-line bulk bag filling system

Leading materials handling specialist, Spiroflow, an Automated Handling Solutions (AHS) company, has launched a next-generation twin-line bulk bag filling system. Following extensive research and development, the new system addresses the limitations of slow, outdated equipment that was prone to spillages and excessive product and dust emissions.

Introducing several key features that significantly enhance production capacity, weigh accuracy and operator ergonomics, the twin-line system is able to handle up to 20 x 500kg bulk bags per hour on each process line - a total of 40 bulk bags. Weigh accuracy is a key aspect of the new system as it achieves an impressive -0/+500g per bulk bag - this precision ensures consistent and accurate filling of each bag, minimising product waste and optimising inventory management processes.
One of the system’s notable design innovations is the incorporation of a raising and lowering filling head, specifically engineered to improve the ergonomic load of empty bags for operators. This feature aims to enhance operator comfort and safety, reducing the risk of workplace injuries.
The integration of auto-release hooks and roller conveyors streamlines the entire filling process, allowing for seamless and automated transfer of full bulk bags from the filler to the conveyors. This automation minimises the need for manual intervention, further enhancing efficiency.
With a strong emphasis on housekeeping, each filler is equipped with an integrated and independent dust extraction and filter system. This ensures that product and dust emissions are minimised, maintaining a clean and safe workspace for both operators and the environment.
The system includes a customised platform design that complements its functions and facilitates operator workflows to optimise operational efficiency. This design consideration ensures smooth operations and enhances the overall performance of the filling system.
The inclusion of an automated roller conveyor system enables the smooth transfer of full
bulk bags throughout the entire system, significantly reducing the need for manual handling and increasing overall throughput. In addition, the auto-dispensing pallet system efficiently places the pallet in position before loading the empty bag, simplifying the bag-loading process and saving valuable operator time.
Safety is a top priority in the design of the new bulk bag-filling system. The equipment is fully enclosed with safety fencing and features interlocked access gates to prevent unauthorised access while ensuring that the equipment operates safely and efficiently.
The new bulk bag filling system combines enhanced production capacity, precise weigh accuracy, ergonomic design, automation, safety features, and customised platform design to create a state-of-the-art filling solution that optimises efficiency, minimises waste and ensures a safe working environment.
“We are excited to introduce this revolutionary double bulk bag filling system, which addresses our clients’ needs for increased productivity, accuracy, and safety,” said Spiroflow’s Rhodri Jones. “This advanced technology not only enhances operations, but also contributes to a more sustainable and efficient working environment. The new system is currently in use with a powder manufacturing company, where it has considerably improved throughput, safety and efficiency.”
Automated Handling Solutions (AHS), is set to join forces with Advanced Material Processing (AMP), integrating Kason Corporation and Marion Process Solutions, to showcase their material processing equipment and solutions on stand F54 at the PPMA show, at Birmingham’s NEC, UK and on stand 4-309 at POWTECH, Nuremberg, Germany, both between the 26-28 September.
Bag Filling Systems
PPMA 2023 14 | foodanddrinknetwork-uk.co.uk
For more information
on Spiroflow, please visit www.spiroflow.com
The twin-line bulk bag filling system
Global supplier of cartoning and sleeving solutions

Simple, reliable and robust cartoning and sleeving machinery that is easy to operate, hygienically designed and proven worldwide.
Solutions
Our commitment to continuous improvement and innovation has resulted in the introduction of some market leading solutions for our customers. Our patented Preglued Sleever and unique slimline Auto Cartoner remain market leading machines in the food industry while our range of specifically developed beverage machines are now firmly placed as the favourite within the craft brewery industry.
Simple, robust and reliable Food Industry Solutions
Through years of experience our range of food packaging machinery has been refined to be easy to understand and operate while being reliable and robust to meet the most stringent demands. Our range of Cartoning and Sleeving machines are used worldwide packing a huge range of food products including chilled ready meals and desserts, dairy products, meat free alternatives, frozen convenience foods, bakery and pastry goods, soups and sauces and a wide range of confectionery.
UK designed and built Beverage Multi-pack Machinery

Our specifically developed range of Beverage Multipack Machinery is designed to suit most small to medium bottling and canning operations. All our equipment is easily visible with open access for both cleaning and routine maintenance and manufactured to meet the specific demands of the beverage and craft brewing industry. We offer small starter machines through to fully automatic high throughput equipment.
Other mail order, household goods, hardware, personal care applications
Our simple and adaptable machines have been used for packing products from laundry tabs to circuit boards. Our robust build coupled with the very best materials and the finest components results in dependable and reliable equipment that needs only the minimum of routine maintenance to deliver unequalled performance no matter what product is being packed.

Cartoning & Sleeving PPMA 2023 foodanddrinknetwork-uk.co.uk | 15 For more information please visit tfreemantle.com

The Highlight of the UK Packaging Industry
Are you ready for the biggest event in the UK packaging industry? London Packaging Week, organised by Easyfairs, is fast approaching, promising an unforgettable experience on September 21 & 22.

Easyfairs London Packaging Week
With exhibitors showcasing at the Packaging Première, PCD, PLD, and Food & Consumer Pack arenas, London Packaging Week is the ultimate platform for not only showcasing packaging products and innovations, but the latest trends influencing the today’s markets, and providing a valuable network for industry experts. Held at the prestigious ExCeL London Exhibition Centre, this event is a mustattend for packaging professionals from manufacturing through to retail and brand design.
This year, sustainability takes centre stage like never before. London Packaging Week is on a mission to align with the packaging industry in its efforts to move towards a more environmentally responsible future. By collaborating with ExCeL London, a beacon of sustainability with certifications like carbon neutrality and ISO 14001, the event sets new standards for eco-friendly practices in the events industry.
Renan Joel, Director of Packaging at Easyfairs, emphasised the importance of sustainability, stating, “Sustainability is not just a buzzword but a core value within the packaging industry. By partnering with ExCeL London, we demonstrate our commitment to setting higher standards and promoting sustainable practices throughout the event.”
London Packaging Week walks the talk when it comes to sustainability. Through a series of carefully planned initiatives, the event minimises its environmental footprint, including energy conservation, waste management, digital innovation and community engagement.


Visitors can also get ready for the most accessible London Packaging Week yet. With two step-free stations, Custom House and Prince Regent, adjacent to London ExCel, access is made easy and travelling to the venue is simple. Inside, all public entrances have wheelchair-friendly ramps and automatic doors, ensuring unobstructed movement throughout the 600m long central boulevard. With its dedication to accessibility, London Packaging Week at ExCeL London ensures that everyone can fully participate and enjoy the event and with many convenient travel options.
Inspiring Line-Up of Speakers: Learning from the Best
Prepare to be inspired by the incredible line-up of speakers at London Packaging Week. On day one, catch Marisa and Teddie from Perfect Ted as they discuss “Game, Set, and Matcha! How PerfectTed is bringing a new wave of energy to the healthy drinks movement.” Akash Mehta shares insights into “mindful business” in the beauty industry, while Roger Saul reveals his journey “From one bag to another - a British icon’s journey from luxury handbags to a luxury farm.” Jaume Ferras, the Global Creative Director of The Macallan, offers invaluable insights into the world of premium whiskey.
Day two brings even more excitement with Liz Earle MBE sharing her inspiring story. Don’t miss the exclusive live interview with Jamie Laing and Ed Williams, founders of Candy Kittens.
Expect thought-provoking talks from Nestle and WRAP as well as the eagerly anticipated “Plastic Bank on the Big Question” session, which will drive crucial discussions on packaging.
Packaging Startup Awards 2023:
Unveiling the Future Innovators
Get ready to witness the future of packaging innovation at the inaugural Packaging Startup Awards 2023, sponsored by Ocado. The winners across six categories - alternative materials, connected packaging, increased functionality, online, refill & re-use, waste reduction - will be announced during a headline session on 22nd September. A panel of 14 industry experts will judge the entries, providing emerging startup talents with a platform to showcase their ideas and contribute to the packaging industry’s future.
Uniting the industry
London Packaging Week remains at the forefront of the packaging industry, offering an exciting platform for exhibitors and attendees alike. With its commitment to sustainability, innovation, and all things packaging, it remains the must-see event of the UK packaging industry. Don’t miss the opportunity to be part of this dynamic event and to meet with the industries leading experts.
Exhibitions London Packaging Week 2023 foodanddrinknetwork-uk.co.uk | 17
Register at londonpackagingweek.com
today!
Find out what drives the beverage industry worldwide.

Do you want to keep an eye on current topics along the entire process chain of the beverage industry? Then you can‘t miss BrauBeviale in Nuremberg.

The international community of the beverage industry will meet here from 28 – 30 November 2023. Be part of it!
www.braubeviale.de/en
28 – 30 November 2023
Nuremberg, Germany
BrauBeviale in top form
After a 4-year break in its exhibition schedule
BrauBeviale in Nuremberg will start again from November 28-30, 2023.

With a diverse range of exhibitors, precisely designed special areas and a broadly-based support program, visitors from the beer, soft drinks and mineral water industries, as well as from the wine, sparkling wine and spirits industries, will find practical solutions for their operational requirements in process technology, filling and packaging, or in logistics.

At a press conference in Milan, the show organizers presented their program for this year and drew a close connection between the challenging economic environment and the clear responses offered by the show’s overall line-up. The organizers used three key topics to illustrate the current challenges in the beverage industry: In many segments, for example, consumption figures, and correspondingly production figures for many beverages, had not returned to 2019 levels even by the end of 2022. Furthermore, a shortage of appropriately skilled workers in the catering industry was contributing to the fact that out-of-home consumption in particular still had some catching up to do.
Challenging economic environment
There is always movement within the industry, and thus the number of breweries in Europe, with an increase of 614 during 2022, further demonstrates that forward-looking entrepreneurs continue to assess the potential in the European beverage market very positively. At the same time however, the enormous cost increases, which according to a survey by the German Brewers’ Association (Deutscher Brauer Bund), have resulted in a 140 percent increase in the price of new glass, a 135 percent increase in the price of carbon dioxide, and a 150 percent increase in the price of brewing malt, demand a high degree of flexibility in the procurement policies of beverage producers and breweries. In addition, the requirements recently published in the EU’s draft Packaging and Packaging Waste Directive (PPWR) bring new uncertainties, particularly with regard to the development of reusable packaging strategies in Europe.

Solutions at BrauBeviale
Beverage producers and brewers, as well as winemakers, are therefore
well advised to establish a solid basis for their investment programs by means of gathering comprehensive information on raw materials, new machinery, production solutions, or logistics concepts. BrauBeviale offers a comprehensive range of products and services for the entire process chain in nine halls covering approx. 40,000 m² of exhibition space with around 900 exhibitors.
Alone 130 suppliers for packaging, closures, labelling, and secondary packaging will show their solutions for the tasks involved in productappropriate and efficient packaging.
The pressing question of carbon dioxide supply, for example, will be addressed by 17 suppliers and answered with state-of-the-art solutions. Alternatively – raw material topics: answers to questions about securing raw materials can be discussed with a total of 88 suppliers. The product database is already online and can be accessed by all users in the beverage and brewing industry to obtain the comprehensive supplier information even before visiting the event. From July 25, the ticket store will be open so that planning for a visit to BrauBeviale can be easily started online.
Support program for all visitor groups
New in this year’s exhibition portfolio – around 70 percent of exhibitors will include an offering for the customer group winegrowers – is a special show on grape processing and cellar management in Hall 4A. In this way, the exhibition also offers interesting stimuli for operators in wine production. “We are investing in this special area,” explains Andrea Kalrait, Executive Director of BauBeviale, “in order to demonstrate that the range of products and services at BrauBeviale is very broadly diversified and that a visit is therefore also worthwhile for those in the wine industry.” The supporting program will again cover a wide range of topics: “Sustainability in the light of climate and market changes”, “Industry Hotspots Future” to “Corporate profiling via sustainability”, to “Containers, Systems under Pressure” and on to “Raw Materials” demonstrate how brewers and beverage producers or even vintners can deal with the current challenges. The Forum BrauBeviale in Hall 1 is the address for visitors who want to find impulses for this. Furthermore, this is also the address for all visitors with a focus on marketing: “Branding the Brain” or sustainability in brand communication are the current hot topics for all interested parties.
But also the special areas with the Expert Forum, an exhibitor platform in Hall 4 or the Logistics Lounge, (also in Hall 4) will provide for knowledge enhancement and stimulating exchange. With the Craft Drinks Area in Hall 6, BauBeviale once again addresses a broad field of brewers and focuses on individual beer types and ingredients. The perfect place for beer connoisseurs or those who want to become one is the European Beer Star – this year in its 20th iteration. Over 500 breweries from 44 countries are sending entries.
The brewers will showcase their brewing skills and face the critical palate of the jury.
The wide-ranging supporting program, which is free of charge for all visitors, will be available to view online at braubeviale.com from September.
Exhibitions Brau Beviale 2023 foodanddrinknetwork-uk.co.uk | 19
SUSTAINABLE PRODUCTION
Low-Impact Environmental Strategies

Sustainable factories are pioneering a new era of manufacturing by implementing low-impact environmental strategies. These forwardthinking approaches encompass various aspects of production, from sourcing materials to waste disposal. One of the key strategies involves adopting renewable energy sources such as solar and wind power to meet factory energy needs. This reduces reliance on fossil fuels and minimises greenhouse gas emissions, thereby contributing to a cleaner environment.
Additionally, sustainable factories place a strong emphasis on water conservation. Technologies like rainwater harvesting and water recycling systems are implemented to reduce water usage and minimize strain on local water resources. By integrating these practices into their operations, these factories are setting an example for responsible resource management.
Temperature-Controlled Practices



Maintaining optimal temperature conditions is essential for many manufacturing processes, particularly in industries such as












































































pharmaceuticals, food, and electronics. Sustainable factories are leading the way in implementing temperature-controlled practices that not only enhance product quality and safety but also reduce energy consumption.
Advanced HVAC (Heating, Ventilation, and Air Conditioning) systems equipped with smart sensors and energy-efficient components play a pivotal role in achieving precise temperature control. These systems adjust cooling and heating based on real-time data, optimising energy usage and minimizing waste.





Furthermore, innovative insulation materials and designs are employed to create airtight environments that retain temperature efficiently. By reducing heat loss and gain, sustainable factories can significantly cut down on energy demands, contributing to both cost savings and a reduced carbon footprint.

Design Techniques for Energy Efficiency and Waste Minimisation
The design of a factory plays a crucial role in determining its energy efficiency and waste production. Sustainable factories incorporate
Compact, lightweight and mobile • AW Quick for results in 4 – 5 min. • Easy to use with display • Also measures humidity and temperature • Free smartphone app • AwTherm HC2-AW
SCAN ME
HygroLab
Building the Future
20 | foodanddrinknetwork-uk.co.uk
Leading the Way in Environmental Responsibility Auto-report nction
The new AwEasy complements our range of water activity measurement devices perfectly. Measurement probes, penetration probes, laboratory benchtop and handheld devices can be combined flexibly according to your requirements. Bene t from the highest accuracy, e ciency, and easy calibration to optimize processes and ensure product quality. ProcessSensing.com
AwEasy
Rotronic AwEasy – Standalone Bluetooth Water Activity Monitor
intelligent design techniques that focus on maximizing natural lighting, optimizing layouts, and minimizing material waste. Large windows and skylights are strategically placed to capitalize on natural sunlight, reducing the need for artificial lighting during daylight hours. This not only saves energy but also creates a more pleasant and productive working environment for employees. Moreover, innovative layouts are designed to optimise workflow and minimize the distance raw materials and finished products need to travel within the facility. This not only streamlines operations but also reduces energy consumption associated with material handling.
By embracing modular construction and lean manufacturing principles, sustainable factories can minimize material waste during construction and operation. This waste reduction contributes to a more sustainable production process and supports a circular economy.
Supporting the Supply Chain Sustainable factories have a ripple effect that extends beyond their walls, positively impacting the entire supply chain. By prioritizing ecofriendly practices, these factories encourage suppliers to adopt similar principles, leading to a domino effect of sustainable change throughout the industry.
For example, suppliers may be motivated to provide raw materials with reduced carbon footprints, driving innovation in sourcing and production. This, in turn, supports the creation of a greener supply chain that aligns with modern environmental standards.
Sustainable factories are at the forefront of a transformative movement within the manufacturing sector. By implementing low-impact environmental strategies, temperaturecontrolled practices, and intelligent design techniques, these factories are reducing energy consumption, minimizing waste production, and supporting a more sustainable supply chain.


As the world continues to prioritize environmental responsibility, sustainable factories serve as inspiring examples of how industry and sustainability can coexist harmoniously. By building a future that values both production and planet, these factories are driving positive change and setting a new standard for manufacturing excellence.


Sustainable Factories foodanddrinknetwork-uk.co.uk | 21
Top tips to reduce food waste during processing
By Matt Hale, International Sales & Marketing Director, HRS Heat Exchangers


According to some estimates, over a third of all the food produced globally is wasted. The UK generates around 9.5 million tonnes of food waste a year, of which some 1.5 million tonnes (16%) comes from manufacturing1. While not all of this material is edible, in terms of efficiency and reducing greenhouse gas (GHG) emissions, prevention of this waste is preferable to other methods such as food redistribution or use as animal feed, or recycling, energy generation or disposal via anaerobic digestion, composting, incineration or landfill.
Waste food also has significant financial costs for businesses. Not only does the raw material have a cost, but additional costs are associated with the redistribution or disposal of waste food products. Some key areas to consider include:
1. Improve packaging
Good quality packaging improves the shelf life of food and therefore reduces waste in the distribution chain and in households. However, there is increasingly a balance between reducing the use of plastics and non-recyclable materials, while increasing product shelf life (wrapping cucumbers in plastic is a classic example). Choosing the right packaging during the manufacturing process can improve shelf life and reduce handling, improving efficiencies and reducing waste.
2. Improve forecasting
Inaccurate forecasting can mean you waste raw materials and ingredients. Don’t assume that you need to produce a certain number of products unless you have clear evidence for such demand (such as agreed orders or demand modelling). Ordering enough ingredients to produce a certain volume of product but actually producing less, is one of the biggest sources of waste in food businesses, particularly when using fresh or perishable ingredients. Better and more accurate forecasting models allow you to guess less and maximise the use of ingredients.
3. Measure and plan
Without measuring waste, you can’t tell if you are reducing it, or adequately calculate what it is costing you. Feeding this data into company-wide systems so that it can be analysed centrally helps to identify areas of inefficiency and waste, allowing manufacturers to streamline processes and reduce waste.

HRS Heat
22 | foodanddrinknetwork-uk.co.uk
Exchangers
Careful equipment choice can help to reduce food waste
Matt Hale, International Sales & Marketing Director, HRS Heat Exchangers
4. Review quality control systems
Quality control is vital to maintain standards and food safety, but there is a need to avoid overzealous standards which may result in ingredients which are perfectly usable being discarded. Likewise, under- or overcooking-food, or having unnecessary trimmings or off-cuts results in unnecessary waste.
As well as making sure that the quality standards and specifications being applied are appropriate for the product, it is also important to make sure that the processes used for quality assurance are operating correctly, whether that is calibrating equipment or training staff.
5. Involve staff
As with other areas, staff awareness, education and involvement play a huge role in minimising waste. Employees should be invested and committed to reducing waste and building it into company culture. As well as educating staff about the impacts of waste, they should be encouraged to take part in a full dialogue as employees often have useful insights.
6. Improve ‘disposal’ of unavoidable waste
Even with the best will in the world, some ‘waste’ is likely to be generated. This should be dealt with in a way which maximises its usefulness or value. According to the food waste hierarchy, in order of preference these disposal options are:

a. Redistribution to people
b. Use for animal feed
c. Anaerobic digestion
d. Composting
e. Incineration with energy recovery
f. Incineration, landfill or disposal via sewerage systems

It may also be possible to utilise certain products in novel ways, for example vegetable oils and animal by-products (ABPs) can be converted into biodiesel where facilities allow.
7. Use technology to reduce waste during production
New technology or equipment may help increase utilisation, for example by recovering more usable protein from meat carcases. Another option is to optimise existing production processes, particularly when it comes to production changes or cleaning-in-place (CIP).

For example, the HRS R Series of heat exchangers uses a scraper bar within the inner tube to enhance product flow, prevent fouling and minimise pressure drop. It has the unique feature that when configured correctly, the unit can be run in reverse, effectively emptying the heat exchanger tube(s) of product without damaging it or changing its characteristics, so it can be recovered and utilised.
Due to the amount of product saved, and the fact that it is often unnecessary to install additional product recovery systems, the R Series heat exchanger can quickly pay for itself, and in the long term can be a more economic option than alternative systems which have lower capital costs.
Sustainable Factories foodanddrinknetwork-uk.co.uk | 23
The HRS R Series can be run in reverse, effectively emptying the heat exchanger tube(s) of product
Consider how you dispose of unavoidable waste. For example, anaerobic digestion is preferable to landfill
CORROSION RESISTANT SOLUTIONS FROM


In an environment of increased operational requirements and tough regulatory guidelines, today’s bearings and power transmission products are exposed to a host of demanding conditions. Such conditions may include corrosive cleaning agents, high pressure washdown and a wide array of environmental factors that can negatively impact performance. Overall, a balance of material strength, corrosion resistance, sealing and lubrication are required for all products used where hygiene is of paramount importance.


Due to the pandemic we’ve seen increased attention to cleanliness, washdown procedures and prevention of foreign contaminants from getting into the manufacturing process within fish, food and beverage processing companies. Recently there has been concern over a rise in contamination in meat processing and fruits and vegetables; which has changed procedures in food manufacturing across the board.

Cross & Morse 24 | foodanddrinknetwork-uk.co.uk
Stainless steel tends to hold up the best, allowing for more pressure, more soap and a little faster cleaning time. Alternative surface treatments such as nickel plating and Aquaproof are also available.
There is tremendous benefit to selecting products that support a reduced maintenance schedule. For example, corrosion resistant high performance bearings can prevent contaminants such as water and dirt from entering the bearing. New equipment is not always an option, so the ability to adapt to the situation with the right components with the best seals can be a game-changer.
Corrosion Resistant Products
Introducing CRS from Cross+Morse: a comprehensive line of corrosion resistant power transmission products engineered to perform in corrosive and contaminated environments.
Cross+Morse offer an entire range of stainless steel products suitable for washdown environments: Roller chain and attachments, sprockets, taper bushes, shaft clamping elements;

There is tremendous benefit to selecting products that support a reduced maintenance schedule. For example, corrosion resistant high performance bearings can prevent contaminants such as water and dirt from entering the bearing. New equipment is not always an option, so the ability to adapt to the situation with the right components with the best seals can be a game-changer.
Corrosion Resistant Components
For further information please contact Cross+Morse
Telephone: +44 (0) 121 360 0155

Facsimile: +44 (0) 121 325 1079
Email: sales@crossmorse.com or visit www.crossmorse.com
along with the whole selection of McGill® cam followers and Sealmaster® bearings and gearboxes.


If there is not an off the shelf solution, Cross+Morse also have the ability to manufacture sprockets, platewheels, gears, bevel gears, helical gears and timing belt pulleys in non-corrosive material to your exact specifications at our factory here in Birmingham.



foodanddrinknetwork-uk.co.uk | 25
Online Machinery Auctions


Transforming the Buying and Selling of Production Equipment

The food and drink industry is a dynamic and ever-evolving landscape, marked by constant innovation and the need for state-of-the-art production equipment. In recent years, a transformative shift has occurred in the way businesses in this sector buy and sell machinery - online food machinery auctions have emerged as a game-changing solution.
Companies like Industrial Auctions and Eddisons CJM are leading the charge in this digital revolution, providing a platform that redefines the process of acquiring and offloading production equipment. Let’s delve into the remarkable impact of online machinery auctions on the food and drink industry.
A New Era of Convenience and Efficiency

Traditional methods of buying and selling production equipment often involve time-consuming processes, including negotiations, physical inspections, and extensive paperwork. Online machinery auctions disrupt this paradigm by offering a streamlined and efficient alternative. Through a few clicks,

participants can access a wide range of machinery listings, place bids, and manage transactions—all from the comfort of their offices or homes.
Industrial Auctions and Eddisons CJM are pioneers in this digital transformation. These platforms curate comprehensive catalogues of food and drink production equipment, ranging from processing machinery to packaging solutions. Buyers gain real-time insights into available equipment, enabling them to make informed decisions quickly and efficiently. Sellers, on the other hand, benefit from a global audience of potential buyers, maximizing their chances of securing a favourable deal.
E: accounts@eddisonscjm.com



T: +44(0)1724 334411
W: w w w.eddisons.com
Whether it be a complete factor y or a single machine, Eddisons have the experience and exper tise you can trust, our Online Auctions give global exposure and optimum returns at minimum cost.

Swift, cost effective and transparent, the Online Auction allows our clients to quickly conver t redundant commercial & industrial assets in to cash.

for

Cost-Effective Machinery Purchases
26 | foodanddrinknetwork-uk.co.uk
Catalogues, bidding and FAQs are available through our website
Valuers
YOU KNOW? 10M+ OVER 10M PEOPLE SAW OUR ONLINE AUCTIONS LAST YEAR
Industrial Auctioneers and
DID
What
happens with your Surplus, Redundant Machines, Stock & Excess Inventor y?
we can assist you to generate cash from surplus assets. +44(0)1724
Paul.Cooper@eddisons.com nAuctioneering nWorkshop & Factor y Clearances nDismantling, Packing & Shipping General Services Adverts_Machinery Trader HP 24/03/2022 10:54 Page 1
Contact us now
a no obligation discussion as to how
334411 -
Unlocking Global Opportunities
Online machinery auctions transcend geographical boundaries, opening doors to a global marketplace for both buyers and sellers. The food and drink industry is inherently diverse, with specialised equipment needs varying from one region to another. Online auctions facilitate the connection between businesses looking to offload equipment they no longer need and those seeking specialized machinery to enhance their operations.


Industrial Auctions and Eddisons CJM capitalize on this global reach, allowing businesses to access a vast network of potential partners, suppliers, and clients. This interconnectedness fosters a vibrant ecosystem where surplus equipment can find new life, and innovative solutions can find their way to markets that need them the most.
Transparency and Fair Market Value

One of the hallmarks of online machinery auctions is the transparency they bring to the buying and selling process. Through detailed equipment descriptions, high-quality images, and comprehensive documentation, participants have access to all the information they need to make informed decisions. This transparency extends to the bidding process itself, as real-time updates enable buyers to gauge market demand and adjust their bids accordingly.
Furthermore, online auctions promote a competitive environment that often results in fair market value for production equipment. Bidders have a clear understanding of the prevailing market rates, ensuring that both buyers and sellers benefit from a balanced and equitable transaction.

Sustainability and Circular Economy
The food and drink industry’s growing emphasis on sustainability aligns seamlessly with the principles of online machinery auctions. By facilitating the resale and repurposing of production equipment, these platforms contribute to a circular economy, reducing waste and promoting resource efficiency. Equipment that may no longer serve its original purpose for one business can find new life in another, minimizing the environmental impact of disposal.

Food Machinery Auctions foodanddrinknetwork-uk.co.uk | 27
CONSIDERING AN INSTANT BUILDING?

Smart-Space is the UK’s largest independent supplier of instant buildings and has designed and installed all kinds of instant warehouses, workshops, storage spaces, canopies and loading bays. They’re something of an authority on instant buildings having been in the sector for over thirty years.



As well as fulfilling changing business needs, instant buildings sometimes just make better financial sense, especially when you anticipate the need well in advance but are less sure of how long you’ll need the solution for.
With these factors in mind, what do you need to know before taking the next steps in considering an instant building?
1 RESPONSE TIMES: If you are in a hurry to meet a specific business need, ask your proposed supplier how long it will take to be ready to use – from order to handing over the key, it should only be a few short weeks. The speed of an instant building is largely down to the experienced team, the building’s modular structure and (usually) no foundations being required.
2 PLANNING: Ask about planning requirements – these are
dependent on several different criteria and, contrary to popular belief, it’s hardly ever a ‘one solution fits all’ answer. Smart-Space has its own planning department who can advise on exactly what is likely to be acceptable for successful planning approval. You can also consider retrospective planning permission if you are in a real hurry and confident it will pass.
by Shaun Stephens, UK Sales Manager, Smart-Space
Smart-Space 28 | foodanddrinknetwork-uk.co.uk
Here are 10 key things you need to consider…
3 FIT FOR PURPOSE: Understand all the uses for your building. Will people need to work inside for extended periods of time? Will any stored products require consistent temperatures? The different uses for a building determine the type you need and you should be offered the right solution for your needs, not just the one the supplier happens to stock. You might like to also check if your building can be relocated, extended or reduced in size allowing you to make further decisions about adapting the space during your hire term.

4 OFF-HIRING: Smart-Space requires 7-days’ notice to off-hire at any point during the contract believing that there is no point holding a customer to an agreement that no longer suits them. Make sure you are able to build in some flexibility within your terms so you can adapt if your business needs change.
5 HIRE OR BUY: If you are hiring and this becomes a longer term prospect, make sure you can switch to purchase when you need to. It is much more cost-effective to buy your instant building if you are planning on keeping it over the long term. Smart-Space will provide the cost comparisons so you are able to predict the point at which you might want to consider changing your terms.
6 SUPPLY CHAIN: Where will your instant building come from? If it’s from overseas you may have to wait for supplies to become available – and also any maintenance might not be available instantly on request. It’s one of the reasons Smart-Space supports buying British as relationships are easier to create and maintain - and they can source stock and support customers on demand.
7 SITE SURVEYS: Don’t accept a project proposal unless you’ve had someone from the supplier visit you to assess the site, make suggestions and check your utilities and groundworks. This is where unexpected costs can creep in and delays can also result if there are unforeseen problems. There is no substitution for a site visit and project that is well planned. Our team can also produce skilled CAD drawings that bring your vision to life – useful for planning permission and to help you through the process.
8 PREVIOUS WORK: Ask to see case studies on completed projects and find out what kind of expertise your supplier has in your sector. It’s vital to understand the needs of your own site within the context of your sector. Smart-Space has worked in schools, nuclear power plants, airside at airports and in any number of emergency and sensitive situations. It’s important that you feel confident in your supplier’s health and safety protocols and consideration of your own work practices before allowing them on-site.
9 WORKFORCE: Following on from point 8, ask if the installation team is directly employed by your proposed supplier. This is key as all directly employed teams carry responsibility for any risk whilst on your premises. If they are sub-contracted the customer has to shoulder complete liability.
10 GOOD TO DO BUSINESS WITH: And finally, are your instant building suppliers good to work with? Do they answer your calls and emails promptly? Are they pro-active, ask questions, visit site and communicate every stage of the process with you? If the business relationship feels right, it probably is.
Smart-Space, based in the Midlands, always puts the customer first and finds that this culture leads to repeat business and loyal customers. They have worked extensively within the food and drink sector and have experience of all kinds of build from ‘off the shelf’ to bespoke solutions.


For further information about Smart-Space please visit smart-space.co.uk

Instant Building Installations foodanddrinknetwork-uk.co.uk | 29
R-Biopharm Group – dedicated to food safety
R-Biopharm Group – dedicated to food safety

R-Biopharm – dedicated to food safety
Tailored mycotoxin testing for your needs


Tailored
Mycotoxin test kits
mycotoxin testing for your needs
Mycotoxin test kits

The test systems can be used for screening purposes or to quantitivately detect all legislated mycotoxins either separately or in group.
• From on-site testing to automated high throughput testing
• From on-site testing to automated high throughput testing
The test systems can be used for screening purposes or to quantitivately detect all legislated mycotoxins either separately or in group.
• LFD, ELISA, SPE, IAC, reusable cartridges
R-Biopharm’s products are a valuable tool to check if your food and feed comply with legislation.
• LFD, ELISA, SPE, IAC, reusable cartridges
• Single or multi-toxin testing options
• Global provider for test kits and compatible equipment
• Cer tified reference material, standards and control material
https://r-b.io/mycotoxins


25.05.2022 09:14:56
4
Testing &
R-Biopharm
Analysis
Mycotoxins_Overview_Brochure_EN_Short version_2021-02.indd 1 25.05.2022 09:14:56 30 | foodanddrinknetwork-uk.co.uk
In the ever-evolving landscape of the food and drink industry, ensuring the safety and quality of products is paramount. Among the various challenges faced by manufacturers, mycotoxin contamination has emerged as a significant concern.
Ensuring Food Safety: Mycotoxin Testing & Eco-Fill Autoclaves

and fruits. When these contaminated products enter the food supply chain, they pose serious health risks to consumers. Mycotoxin testing plays a crucial role in preventing the distribution of tainted products
Meanwhile, advancements in technology have led to the development of eco-friendly equipment, such as autoclaves, designed to conserve resources without compromising efficiency. One company at the forefront of mycotoxin testing and another pioneering sustainable autoclave technology are R-Biopharm Rhone and Astell Scientific, respectively.
Mycotoxin Testing by R-Biopharm Rhone
Mycotoxins are toxic compounds produced by certain moulds that can contaminate various agricultural products, including grains, nuts,
R-Biopharm Rhone is a leading player in mycotoxin testing within the food and drink industry. The company specializes in developing innovative solutions for mycotoxin detection, providing manufacturers with reliable tools to identify and quantify these harmful compounds. By utilising advanced analytical techniques, such as liquid chromatography and mass spectrometry, R-Biopharm Rhone enables rapid and accurate detection of mycotoxins at various stages of production. This proactive approach empowers food and beverage producers to take appropriate measures to mitigate contamination risks and ensure product safety.
Eco-Fill Autoclaves: Astell Scientific’s Sustainable Solution

Autoclaves are essential equipment in the food and drink industry, used for sterilisation and decontamination processes. Traditionally, autoclaves operate using substantial amounts of power and water, contributing to resource depletion and environmental impact. In response to these concerns, Astell Scientific has developed a revolutionary autoclave technology known as eco-fill.
The eco-fill autoclave is designed with a focus on sustainability, featuring innovations that significantly reduce power and water consumption compared to classic-fill autoclaves. The key differentiator lies in the system’s water usage and management. Classic-fill autoclaves require a constant supply of water, which is heated and used throughout the cycle. In contrast, eco-fill autoclaves utilize a unique recirculation system that recycles and purifies water, reducing consumption by up to 90%. This not only conserves water but also minimizes energy requirements, contributing to a greener and more cost-effective operation.
Astell Scientific’s eco-fill autoclaves align with the industry’s growing emphasis on environmental responsibility and sustainable practices. By adopting this innovative technology, food and drink manufacturers can contribute to reducing their carbon footprint while maintaining stringent sterilization standards.
The food and drink industry is constantly evolving, with advancements in technology and scientific knowledge reshaping its landscape. Mycotoxin contamination remains a critical concern, but companies like R-Biopharm Rhone are making significant strides in mycotoxin testing to ensure the safety of products and consumers. Simultaneously, eco-fill autoclaves developed by Astell Scientific are transforming the way sterilization processes are conducted, allowing manufacturers to operate in a more environmentally friendly and resource-efficient manner.

foodanddrinknetwork-uk.co.uk | 31
The Ultimate Wash from New Interfood Partnership
Interfood customers can now ensure ultimate hygiene for their processing equipment following the announcement that the Buckinghamshire-based business has signed a new partnership agreement with Colussi Ermes.

Operating from a head office in Italy and a satellite operation in the USA, Colussi Ermes is recognised as a global leader in advanced washing systems for the food industry, with more than 6,000 machines in operation throughout the globe.

The company’s extensive knowledge has evolved from over 50 years of working with the food industry, with systems supplied for a range of food processing operations, from meat, poultry and dairy to fruit and vegetables and fish.
The new systems will sit within Interfood’s Thermal Processing and Conditioning Division. Steve Naylor is manager of the Division and comments –
“we are delighted to be representing Colussi Ermes in the UK and Ireland. In addition to the excellent quality of the company’s washing, drying and automating solutions, one thing which particularly impressed us is the attention to detail in minimising washing times. With the food industry quite rightly focused on energy costs sitting at an all-time high, being able to offer high level performance but with substantially reduced energy consumption is a strong message.”
Central to the Colussi Ermes philosophy is building tailor made machines, an approach that ties in with Interfood’s own commitment to supplying solutions designed to the specific requirements of a given customer.
Naylor continues –
“food processing operations can differ quite significantly: floorspace, production capacities, power supply and the type of residue/soiling to be processed are just some of the factors that should be considered. It is not a one-size-fits-all approach but rather one that looks at the specifics of an operation and develops a solution which is designed to optimise results.”
The range of Colussi Ermes equipment Interfood will be offering is extensive, including washers for conveyor belts and filters, crates, knives and blades, racks, sticks, utensils, and tote bins, along with spin drying systems.
Hygiene 32 | foodanddrinknetwork-uk.co.uk Interfood
When we help, the Harford system is built to scale across each factory, from goods-in to despatch. With Harford's MIS/MES solutions, all production-related information is available within a single system. All collected data is analysed, prioritised & distributed to networked factory screens, PCs, laptops, tablets and mobile phones, in real time, so that operators can make immediate adjustments to improve performance. Nothing is left to chance.




See us
26 - 28 SEPTEMBER 2023 NEC, BIRMINGHAM RightFirstTime RightEveryTime Value Added Average Quanti t y V i sion Inspection AutoCoding OEE ShortInterva l Contro l turning data into actionable information Eliminate Risk | Reduce Wastage | Improve E ciency We help factories... by with End-to-End MIS/MES +44 (0)1225 764461 www.harfordcontrol.com
on Stand B46




sales@silverson.co.uk • www.silverson.co.uk • (+44) 1494 786331 High Speed High Shear Mixers Silverson offers a complete range of multipurpose high shear mixers able to perform the widest variety of applications - mixing, emulsifying, homogenising, disintegrating and dissolving - with an efficiency and flexibility unmatched by other machines. Stand E20 Visit us at From Laboratory to Full Scale Production